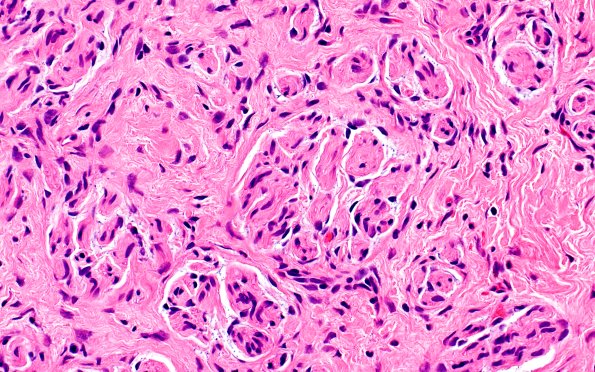
23A3 Neuroma (Case 23) H&E 40X

Table of Contents
Washington University Experience | PERIPHERAL NEUROPATHY | 19 TRAUMATIC INJURIES | 23A3 Neuroma (Case 23) H&E 40X
H&E-stained sections of the nerve biopsy material show an aggregate of innumerable 'mini fascicles' of nerve, consistent with a neuroma. These miniature fascicles are separated from each other by small bands of fibrous tissue, and in some areas appear more as single cells than true fascicles. (H&E)